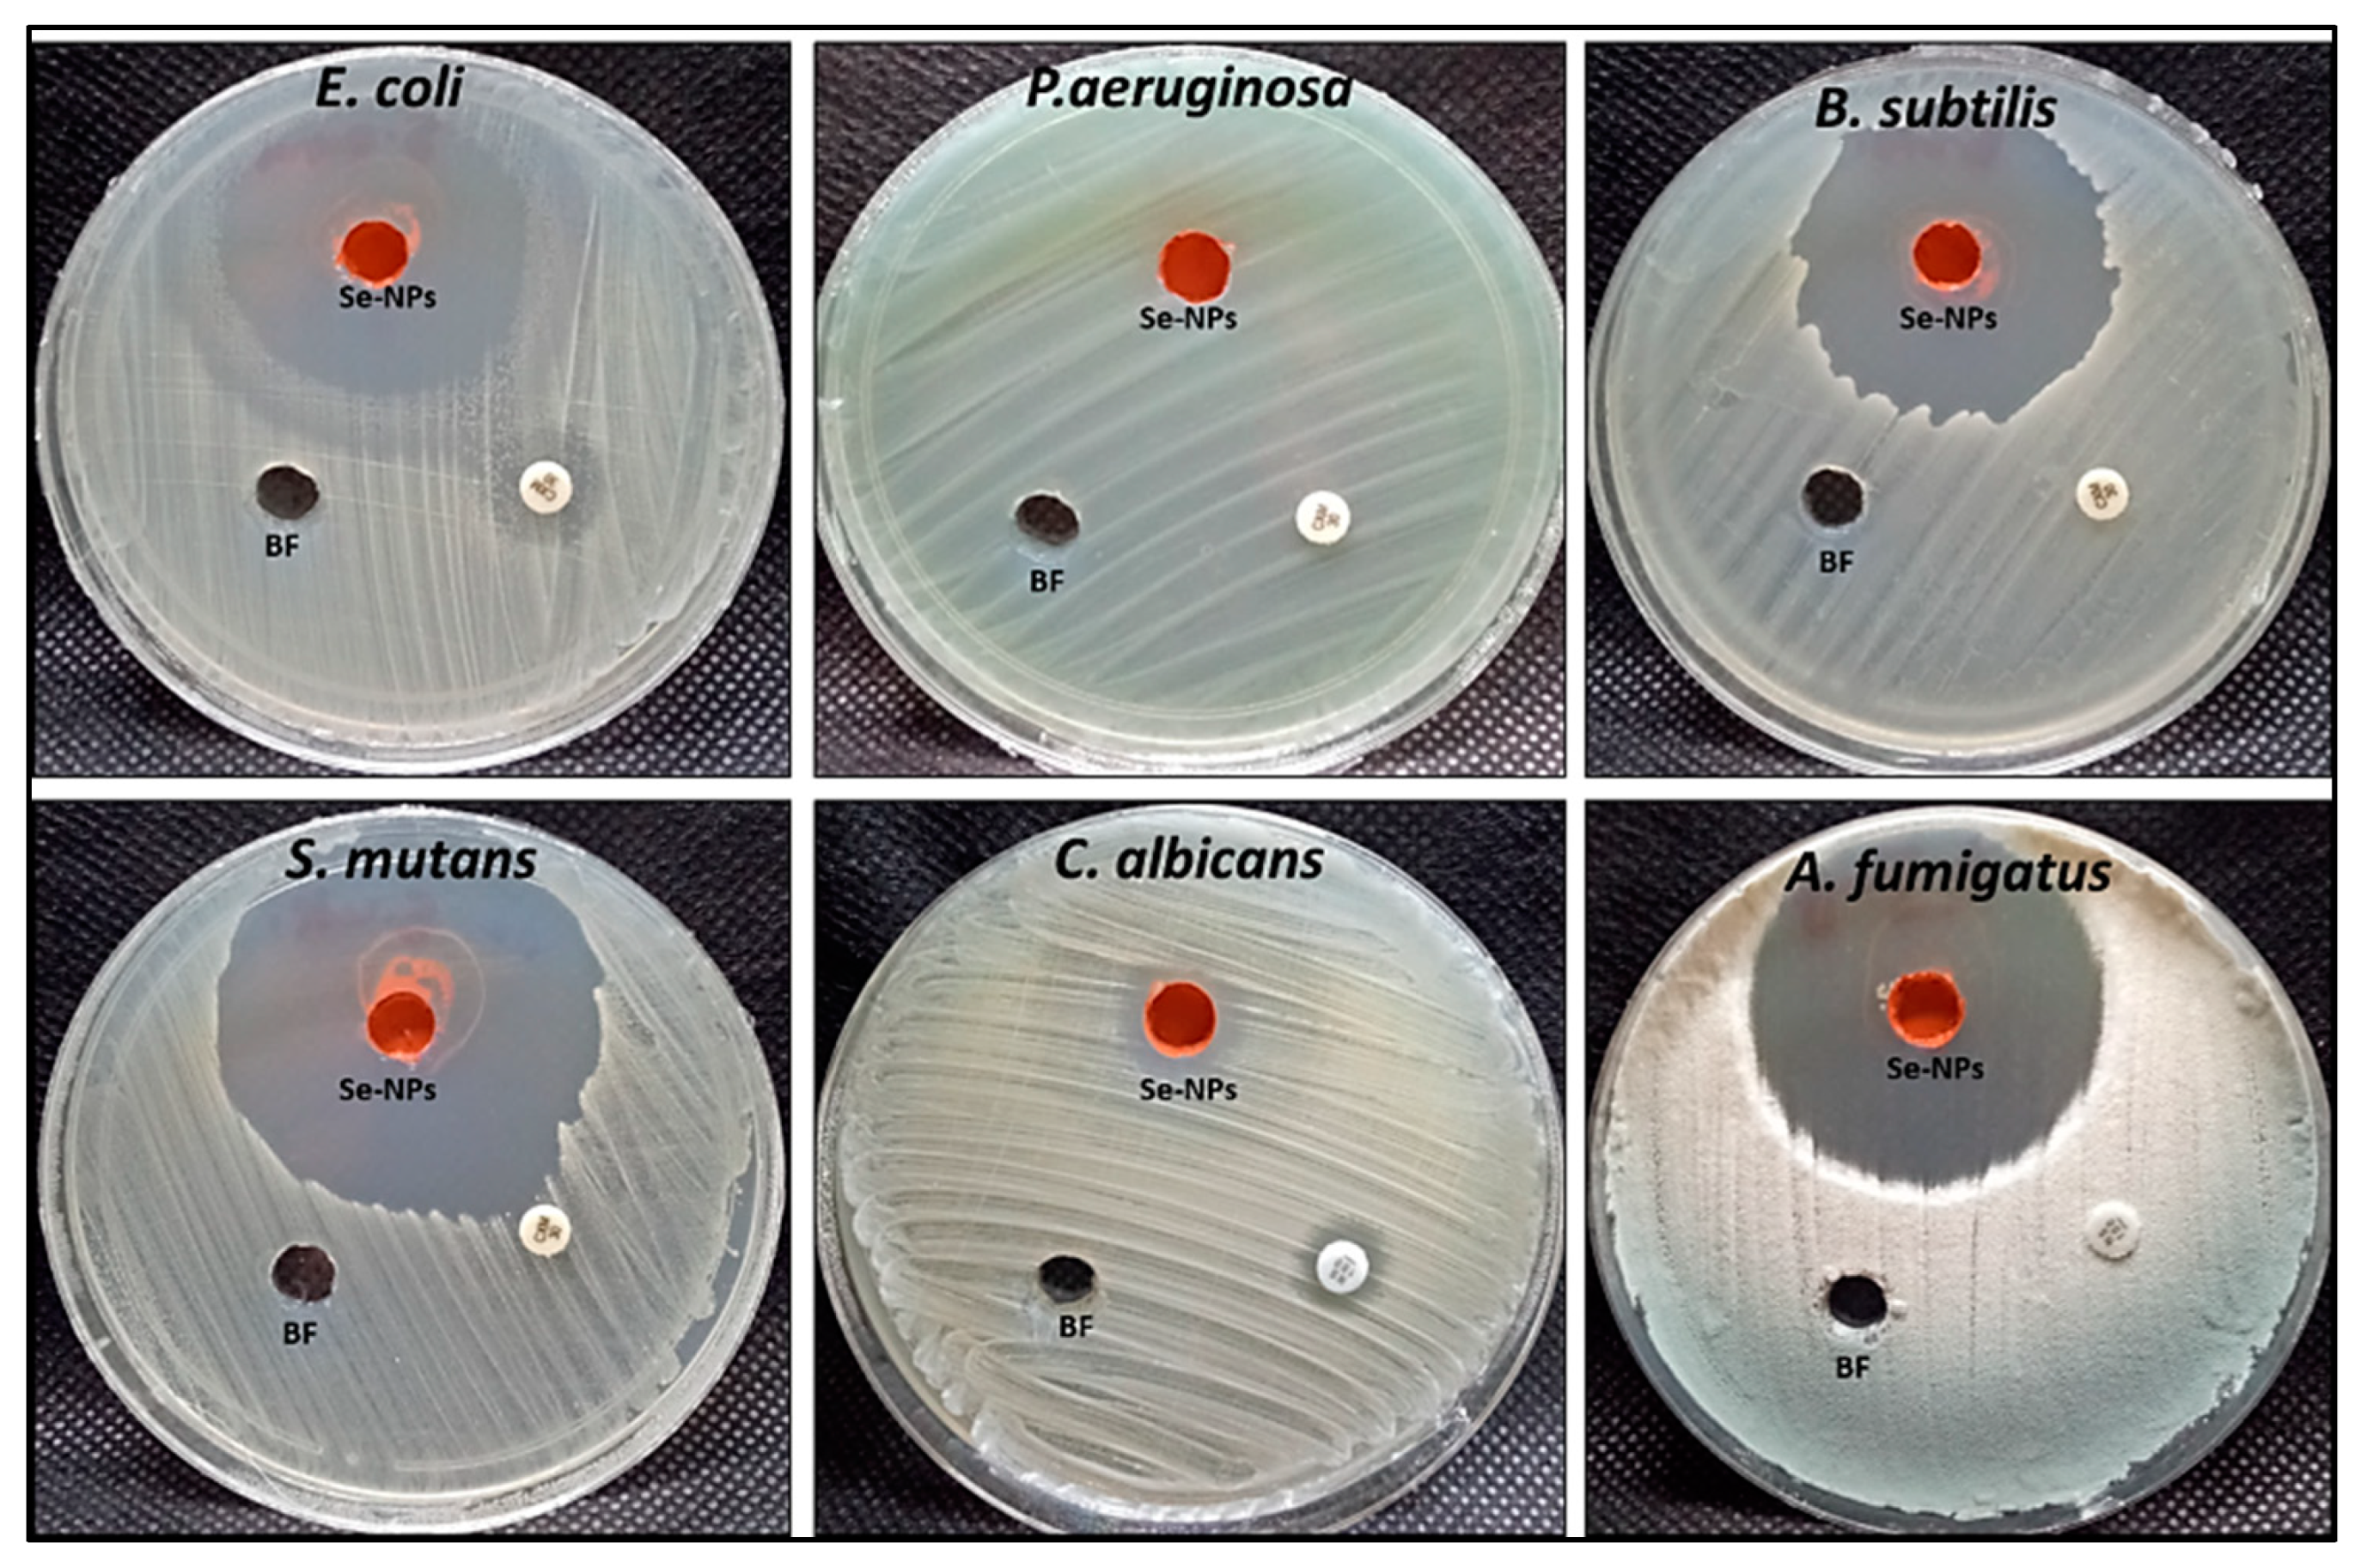
Bioengineering 09 00397 g006

RETRACTED: Mycosynthesis of Hematite (α-Fe2O3) Nanoparticles Using Aspergillus niger and Their Antimicrobial and Photocatalytic Activities
Abstract
:1. Introduction
2. Materials and Methods
2.1. Fungus Used
2.2. Synthesis of Hem-NPs Using a Biomass Filtrate of A. niger AH1
2.3. Effect of Some Physic-Chemical Parameters on Hem-NPs Biosynthesis
2.4. Effect of Incubation Times on the Biomass Filtrate and its Precursor
2.5. Effect of pH Values on the Biomass Filtrate and its Precursor
2.6. Effect of FeSO4·7H2O Concentrations
2.7. Purification of Biosynthesized Hem-NPs
2.8. Characterization of the Optimized Hem-NPs
2.9. Antimicrobial Activity
2.10. Photocatalytic Degradation of Crystal Violet Dye Using Hem-NPs
2.11. Statistical Analysis
3. Result and Discussion
3.1. Green Synthesis of Hematite Nanoparticles (Hem-NPs)
3.2. Factors That Affected the Hem-NP Biosynthesis
3.3. Characterization of Biosynthesized α-Fe2O3 Nanoparticles
3.3.1. UV-Visible Spectroscopy
3.3.2. Fourier-Transform Infrared (FTIR) Spectroscopy
3.3.3. X-ray Diffraction (XRD)
3.3.4. Transmission Electron Microscopy (TEM)
3.3.5. Dynamic Light Scattering (DLS) Analysis
3.4. Antimicrobial Activity of Hem-NPs
3.5. Photocatalytic Degradation of Crystal Violet Dye Using Hem-NPs
3.6. Recyclability of Hem-NPs
4. Conclusions
Author Contributions
Funding
Institutional Review Board Statement
Informed Consent Statement
Data Availability Statement
Acknowledgments
Conflicts of Interest
References
- Vishani, D.B.; Shrivastav, A. Enzymatic decolorization and degradation of azo dyes. In Development in Wastewater Treatment Research and Processes; Elsevier: Amsterdam, The Netherlands, 2022; pp. 419–432. [Google Scholar]
- Sridevi, M.; Nirmala, C.; Jawahar, N.; Arthi, G.; Vallinayagam, S.; Sharma, V.K. Role of nanomaterial’s as adsorbent for heterogeneous reaction in waste water treatment. J. Mol. Struct. 2021, 1241, 130596. [Google Scholar] [CrossRef]
- Kishor, R.; Purchase, D.; Saratale, G.D.; Saratale, R.G.; Ferreira, L.F.R.; Bilal, M.; Chandra, R.; Bharagava, R.N. Ecotoxicological and health concerns of persistent coloring pollutants of textile industry wastewater and treatment approaches for environmental safety. J. Environ. Chem. Eng. 2021, 9, 105012. [Google Scholar] [CrossRef]
- Elgarahy, A.; Elwakeel, K.; Mohammad, S.; Elshoubaky, G. A critical review of biosorption of dyes, heavy metals and metalloids from wastewater as an efficient and green process. Clean. Eng. Technol. 2021, 4, 100209. [Google Scholar] [CrossRef]
- Ahmed, N.E.; Salem, S.S.; Hashem, A.H. Statistical optimization, partial purification, and characterization of phytase produced from talaromyces purpureogenus nsa20 using potato peel waste and its application in dyes de-colorization. Biointerface Res. Appl. Chem. 2022, 12, 4417–4431. [Google Scholar] [CrossRef]
- El-Aswar, E.I.; Ramadan, H.; Elkik, H.; Taha, A.G. A comprehensive review on preparation, functionalization and recent applications of nanofiber membranes in wastewater treatment. J. Environ. Manag. 2022, 301, 113908. [Google Scholar] [CrossRef] [PubMed]
- Crini, G.; Lichtfouse, E.; Wilson, L.D.; Morin-Crini, N. Conventional and non-conventional adsorbents for wastewater treatment. Environ. Chem. Lett. 2019, 17, 195–213. [Google Scholar] [CrossRef]
- Selim, M.T.; Salem, S.S.; Mohamed, A.A.; El-Gamal, M.S.; Awad, M.F.; Fouda, A. Biological treatment of real textile effluent using aspergillus flavus and fusarium oxysporium and their consortium along with the evaluation of their phytotoxicity. J. Fungi 2021, 7, 193. [Google Scholar] [CrossRef]
- Salem, S.S.; Hammad, E.N.; Mohamed, A.A.; El-Dougdoug, W. A Comprehensive Review of Nanomaterials: Types, Synthesis, Characterization, and Applications. Biointerface Res. Appl. Chem. 2022, 13, 41. [Google Scholar] [CrossRef]
- Salem, S.S.; Fouda, A. Green Synthesis of Metallic Nanoparticles and Their Prospective Biotechnological Applications: An Overview. Biol. Trace Elem. Res. 2021, 199, 344–370. [Google Scholar] [CrossRef]
- Patel, P.; Nandi, A.; Jha, E.; Sinha, A.; Mohanty, S.; Panda, P.K.; Mishra, S.; Verma, S.K.; Suar, M. Magnetic nanoparticles: Fabrication, characterization, properties, and application for environment sustainability. In Magnetic Nanoparticle-Based Hybrid Materials; Elsevier: Amsterdam, The Netherlands, 2021; pp. 33–64. [Google Scholar]
- Salem, S.S. Bio-fabrication of Selenium Nanoparticles Using Baker’s Yeast Extract and Its Antimicrobial Efficacy on Food Borne Pathogens. Appl. Biochem. Biotechnol. 2022, 194, 1898–1910. [Google Scholar] [CrossRef]
- Abd Elkodous, M.; El-Husseiny, H.M.; El-Sayyad, G.S.; Hashem, A.H.; Doghish, A.S.; Elfadil, D.; Radwan, Y.; El-Zeiny, H.M.; Bedair, H.; Ikhdair, O.A. Recent advances in waste-recycled nanomaterials for biomedical applications: Waste-to-wealth. Nanotechnol. Rev. 2021, 10, 1662–1739. [Google Scholar] [CrossRef]
- Elbahnasawy, M.A.; Shehabeldine, A.M.; Khattab, A.M.; Amin, B.H.; Hashem, A.H. Green biosynthesis of silver nanoparticles using novel endophytic Rothia endophytica: Characterization and anticandidal activity. J. Drug Deliv. Sci. Technol. 2021, 62, 102401. [Google Scholar] [CrossRef]
- Elbasuney, S.; El-Sayyad, G.S.; Tantawy, H.; Hashem, A.H. Promising antimicrobial and antibiofilm activities of reduced graphene oxide-metal oxide (RGO-NiO, RGO-AgO, and RGO-ZnO) nanocomposites. RSC Adv. 2021, 11, 25961–25975. [Google Scholar] [CrossRef] [PubMed]
- Hasanin, M.; Al Abboud, M.A.; Alawlaqi, M.M.; Abdelghany, T.M.; Hashem, A.H. Ecofriendly Synthesis of Biosynthesized Copper Nanoparticles with Starch-Based Nanocomposite: Antimicrobial, Antioxidant, and Anticancer Activities. Biol. Trace Elem. Res. 2021, 200, 2099–2112. [Google Scholar] [CrossRef]
- Hasanin, M.; Elbahnasawy, M.A.; Shehabeldine, A.M.; Hashem, A.H. Ecofriendly preparation of silver nanoparticles-based nanocomposite stabilized by polysaccharides with antibacterial, antifungal and antiviral activities. BioMetals 2021, 34, 1313–1328. [Google Scholar] [CrossRef]
- Hashem, A.H.; Al Abboud, M.A.; Alawlaqi, M.M.; Abdelghany, T.M.; Hasanin, M. Synthesis of Nanocapsules Based on Biosynthesized Nickel Nanoparticles and Potato Starch: Antimicrobial, Antioxidant, and Anticancer Activity. Starke 2022, 74, e2100165. [Google Scholar] [CrossRef]
- Hashem, A.H.; Salem, S.S. Green and ecofriendly biosynthesis of selenium nanoparticles using Urtica dioica (stinging nettle) leaf extract: Antimicrobial and anticancer activity. Biotechnol. J. 2021, 17, 2100432. [Google Scholar] [CrossRef]
- Al-Rajhi, A.M.H.; Salem, S.S.; Alharbi, A.A.; Abdelghany, T.M. Ecofriendly synthesis of silver nanoparticles using Kei-apple (Dovyalis caffra) fruit and their efficacy against cancer cells and clinical pathogenic microorganisms. Arab. J. Chem. 2022, 15, 103927. [Google Scholar] [CrossRef]
- Mazari, S.A.; Ali, E.; Abro, R.; Khan, F.S.A.; Ahmed, I.; Ahmed, M.; Nizamuddin, S.; Siddiqui, T.H.; Hossain, N.; Mubarak, N.M. Nanomaterials: Applications, waste-handling, environmental toxicities, and future challenges–A review. J. Environ. Chem. Eng. 2021, 9, 105028. [Google Scholar] [CrossRef]
- Hammad, E.N.; Salem, S.S.; Mohamed, A.A.; El-Dougdoug, W. Environmental Impacts of Ecofriendly Iron Oxide Nanoparticles on Dyes Removal and Antibacterial Activity. Appl. Biochem. Biotechnol. 2022. [Google Scholar] [CrossRef]
- Leonel, A.G.; Mansur, A.A.; Mansur, H.S. Advanced functional nanostructures based on magnetic iron oxide nanomaterials for water remediation: A review. Water Res. 2021, 190, 116693. [Google Scholar] [CrossRef] [PubMed]
- Annu, A.A.; Ahmed, S. Green synthesis of metal, metal oxide nanoparticles, and their various applications. Handb. Ecomater. 2018, 2018, 1–45. [Google Scholar]
- LaGrow, A.P.; Besenhard, M.O.; Hodzic, A.; Sergides, A.; Bogart, L.K.; Gavriilidis, A.; Thanh, N.T.K. Unravelling the growth mechanism of the co-precipitation of iron oxide nanoparticles with the aid of synchrotron X-ray diffraction in solution. Nanoscale 2019, 11, 6620–6628. [Google Scholar] [CrossRef] [PubMed]
- Parashar, M.; Shukla, V.K.; Singh, R. Metal oxides nanoparticles via sol–gel method: A review on synthesis, characterization and applications. J. Mater. Sci. Mater. Electron. 2020, 31, 3729–3749. [Google Scholar] [CrossRef]
- Aghazadeh, M.; Ganjali, M.R. Evaluation of supercapacitive and magnetic properties of Fe3O4 nano-particles electrochemically doped with dysprosium cations: Development of a novel iron-based electrode. Ceram. Int. 2018, 44, 520–529. [Google Scholar] [CrossRef]
- Young, C.; Wang, J.; Kim, J.; Sugahara, Y.; Henzie, J.; Yamauchi, Y. Controlled chemical vapor deposition for synthesis of nanowire arrays of metal–organic frameworks and their thermal conversion to carbon/metal oxide hybrid materials. Chem. Mater. 2018, 30, 3379–3386. [Google Scholar] [CrossRef]
- Zhong, G.; Xu, S.; Chen, C.; Kline, D.J.; Giroux, M.; Pei, Y.; Jiao, M.; Liu, D.; Mi, R.; Xie, H. Synthesis of metal oxide nanoparticles by rapid, high-temperature 3D microwave heating. Adv. Funct. Mater. 2019, 29, 1904282. [Google Scholar] [CrossRef]
- Khashan, K.S.; Sulaiman, G.M.; Mahdi, R. The effect of laser energy on the properties of carbon nanotube—iron oxide nanoparticles composite prepared via pulsed laser ablation in liquid. Mater. Res. Express 2018, 5, 105004. [Google Scholar] [CrossRef]
- Ribeiro, A.I.; Dias, A.M.; Zille, A. Synergistic Effects Between Metal Nanoparticles and Commercial Antimicrobial Agents: A Review. ACS Appl. Nano Mater. 2022, 5, 3030–3064. [Google Scholar] [CrossRef]
- Ahmed, S.F.; Mofijur, M.; Rafa, N.; Chowdhury, A.T.; Chowdhury, S.; Nahrin, M.; Islam, A.S.; Ong, H.C. Green approaches in synthesising nanomaterials for environmental nanobioremediation: Technological advancements, applications, benefits and challenges. Environ. Res. 2022, 204, 111967. [Google Scholar] [CrossRef]
- Nagajyothi, P.C.; Prabhakar Vattikuti, S.V.; Devarayapalli, K.C.; Yoo, K.; Shim, J.; Sreekanth, T.V.M. Green synthesis: Photocatalytic degradation of textile dyes using metal and metal oxide nanoparticles-latest trends and advancements. Crit. Rev. Environ. Sci. Technol. 2020, 50, 2617–2723. [Google Scholar] [CrossRef]
- Goutam, S.P.; Saxena, G.; Roy, D.; Yadav, A.K.; Bharagava, R.N. Green synthesis of nanoparticles and their applications in water and wastewater treatment. In Bioremediation of Industrial Waste for Environmental Safety; Springer: Berlin/Heidelberg, Germany, 2020; pp. 349–379. [Google Scholar]
- Fouad, D.E.; Zhang, C.; El-Didamony, H.; Yingnan, L.; Mekuria, T.D.; Shah, A.H. Improved size, morphology and crystallinity of hematite (α-Fe2O3) nanoparticles synthesized via the precipitation route using ferric sulfate precursor. Results Phys. 2019, 12, 1253–1261. [Google Scholar] [CrossRef]
- Hasanin, M.; Hashem, A.H.; Lashin, I.; Hassan, S.A. In vitro improvement and rooting of banana plantlets using antifungal nanocomposite based on myco-synthesized copper oxide nanoparticles and starch. Biomass Convers. Biorefinery 2021, 1–11. [Google Scholar] [CrossRef]
- Zakariya, N.A.; Majeed, S.; Jusof, W.H.W. Investigation of antioxidant and antibacterial activity of iron oxide nanoparticles (IONPS) synthesized from the aqueous extract of Penicillium spp. Sens. Int. 2022, 3, 100164. [Google Scholar] [CrossRef]
- Dash, P.; Raut, S.; Jena, M.; Nayak, B. Harnessing the biomedical properties of ferromagnetic α-Fe2O3 NPs with a plausible formation mechanism. Ceram. Int. 2020, 46, 26190–26204. [Google Scholar] [CrossRef]
- Fouda, A.; Hassan, S.E.-D.; Abdel-Rahman, M.A.; Farag, M.M.; Shehal-deen, A.; Mohamed, A.A.; Alsharif, S.M.; Saied, E.; Moghanim, S.A.; Azab, M.S. Catalytic degradation of wastewater from the textile and tannery industries by green synthesized hematite (α-Fe2O3) and magnesium oxide (MgO) nanoparticles. Curr. Res. Biotechnol. 2021, 3, 29–41. [Google Scholar] [CrossRef]
- Hassan, S.E.-D.; Fouda, A.; Saied, E.; Farag, M.; Eid, A.M.; Barghoth, M.G.; Awad, M.A.; Hamza, M.F.; Awad, M.F. Rhizopus Oryzae-mediated green synthesis of magnesium oxide nanoparticles (MgO-NPs): A promising tool for antimicrobial, mosquitocidal action, and tanning effluent treatment. J. Fungi 2021, 7, 372. [Google Scholar] [CrossRef]
- Fouda, A.; Hassan, S.E.-D.; Saied, E.; Azab, M.S. An eco-friendly approach to textile and tannery wastewater treatment using maghemite nanoparticles (γ-Fe2O3-NPs) fabricated by Penicillium expansum strain (Kw). J. Environ. Chem. Eng. 2021, 9, 104693. [Google Scholar] [CrossRef]
- Fouda, A.; Eid, A.M.; Abdel-Rahman, M.A.; El-Belely, E.F.; Awad, M.A.; Hassan, S.E.-D.; Al-Faifi, Z.E.; Hamza, M.F. Enhanced Antimicrobial, Cytotoxicity, Larvicidal, and Repellence Activities of Brown Algae, Cystoseira crinita-Mediated Green Synthesis of Magnesium Oxide Nanoparticles. Front. Bioeng. Biotechnol. 2022, 10, 849921. [Google Scholar] [CrossRef]
- Standards, N.C.F.C.L. Reference Method for Broth Dilution Antifungal Susceptibility Testing of Yeasts; National Committee for Clinical Laboratory Standards: Wayne, PA, USA, 2002. [Google Scholar]
- Valgas, C.; Souza, S.M.D.; Smânia, E.; Smânia, A. Screening methods to determine antibacterial activity of natural products. Braz. J. Microbiol. 2007, 38, 369–380. [Google Scholar] [CrossRef]
- Dacrory, S.; Hashem, A.H.; Hasanin, M. Synthesis of cellulose based amino acid functionalized nano-biocomplex: Characterization, antifungal activity, molecular docking and hemocompatibility. Environ. Nanotechnol. Monit. Manag. 2021, 15, 100453. [Google Scholar] [CrossRef]
- Oladipo, A.A.; Ifebajo, A.O.; Gazi, M. Magnetic LDH-based CoO–NiFe2O4 catalyst with enhanced performance and recyclability for efficient decolorization of azo dye via Fenton-like reactions. Appl. Catal. B Environ. 2019, 243, 243–252. [Google Scholar] [CrossRef]
- Chatterjee, S.; Mahanty, S.; Das, P.; Chaudhuri, P.; Das, S. Biofabrication of iron oxide nanoparticles using manglicolous fungus Aspergillus niger BSC-1 and removal of Cr (VI) from aqueous solution. Chem. Eng. J. 2020, 385, 123790. [Google Scholar] [CrossRef]
- Srivastava, N.; Srivastava, M.; Alhazmi, A.; Mohammad, A.; Khan, S.; Pal, D.B.; Haque, S.; Singh, R.; Mishra, P.; Gupta, V.K. Sustainable green approach to synthesize Fe3O4/α-Fe2O3 nanocomposite using waste pulp of Syzygium cumini and its application in functional stability of microbial cellulases. Sci. Rep. 2021, 11, 24371. [Google Scholar] [CrossRef] [PubMed]
- Fouda, A.; Awad, M.A.; Eid, A.M.; Saied, E.; Barghoth, M.G.; Hamza, M.F.; Awad, M.F.; Abdelbary, S.; Hassan, S.E.-D. An Eco-Friendly Approach to the Control of Pathogenic Microbes and Anopheles stephensi Malarial Vector Using Magnesium Oxide Nanoparticles (Mg-NPs) Fabricated by Penicillium chrysogenum. Int. J. Mol. Sci. 2021, 22, 5096. [Google Scholar] [CrossRef] [PubMed]
- Mohamed, A.A.; Abu-Elghait, M.; Ahmed, N.E.; Salem, S.S. Eco-friendly mycogenic synthesis of ZnO and CuO nanoparticles for in vitro antibacterial, antibiofilm, and antifungal applications. Biol. Trace Elem. Res. 2021, 199, 2788–2799. [Google Scholar] [CrossRef]
- Mahanty, S.; Bakshi, M.; Ghosh, S.; Chatterjee, S.; Bhattacharyya, S.; Das, P.; Das, S.; Chaudhuri, P. Green synthesis of iron oxide nanoparticles mediated by filamentous fungi isolated from Sundarban mangrove ecosystem, India. BioNanoScience 2019, 9, 637–651. [Google Scholar] [CrossRef]
- Pallela, P.N.V.K.; Ummey, S.; Ruddaraju, L.K.; Gadi, S.; Cherukuri, C.S.; Barla, S.; Pammi, S.V.N. Antibacterial efficacy of green synthesized α-Fe2O3 nanoparticles using Sida cordifolia plant extract. Heliyon 2019, 5, e02765. [Google Scholar] [CrossRef] [PubMed]
- Alagiri, M.; Hamid, S.B.A. Green synthesis of α-Fe2O3 nanoparticles for photocatalytic application. J. Mater. Sci. Mater. Electron. 2014, 25, 3572–3577. [Google Scholar] [CrossRef]
- Karade, V.C.; Parit, S.B.; Dawkar, V.V.; Devan, R.S.; Choudhary, R.J.; Kedge, V.V.; Pawar, N.V.; Kim, J.H.; Chougale, A.D. A green approach for the synthesis of α-Fe2O3 nanoparticles from Gardenia resinifera plant and it’s In vitro hyperthermia application. Heliyon 2019, 5, e02044. [Google Scholar] [CrossRef] [PubMed]
- Vinayagam, R.; Pai, S.; Varadavenkatesan, T.; Narasimhan, M.K.; Narayanasamy, S.; Selvaraj, R. Structural characterization of green synthesized α-Fe2O3 nanoparticles using the leaf extract of Spondias dulcis. Surf. Interfaces 2020, 20, 100618. [Google Scholar] [CrossRef]
- Abbas, H.S.; Akilandeswari, K.; Muddukrishnaiah, K. The antifungal and antiovarian cancer properties of α-Fe2O3 and α-Fe2O3/Zno nanostructures synthesized by Spirulina platensis. IET Nanobiotechnol. 2020, 14, 774–784. [Google Scholar] [CrossRef] [PubMed]
- Yoonus, J.; Resmi, R.; Beena, B. Evaluation of antibacterial and anticancer activity of green synthesized iron oxide (α-Fe2O3) nanoparticles. Mater. Today Proc. 2021, 46, 2969–2974. [Google Scholar] [CrossRef]
- Bashir, A.K.H.; Furqan, C.M.; Bharuth-Ram, K.; Kaviyarasu, K.; Tchokonté, M.B.T.; Maaza, M. Structural, optical and Mössbauer investigation on the biosynthesized α-Fe2O3: Study on different precursors. Phys. E Low-Dimens. Syst. Nanostruct. 2019, 111, 152–157. [Google Scholar] [CrossRef]
- Ahmed, A.; Usman, M.; Yu, B.; Shen, Y.; Cong, H. Sustainable fabrication of hematite (α-Fe2O3) nanoparticles using biomolecules of Punica granatum seed extract for unconventional solar-light-driven photocatalytic remediation of organic dyes. J. Mol. Liq. 2021, 339, 116729. [Google Scholar] [CrossRef]
- Asoufi, H.M.; Al-Antary, T.M.; Awwad, A.M. Green route for synthesis hematite (α-Fe2O3) nanoparticles: Toxicity effect on the green peach aphid, Myzus persicae (Sulzer). Environ. Nanotechnol. Monit. Manag. 2018, 9, 107–111. [Google Scholar] [CrossRef]
- Devi, H.S.; Boda, M.A.; Shah, M.A.; Parveen, S.; Wani, A.H. Green synthesis of iron oxide nanoparticles using Platanus orientalis leaf extract for antifungal activity. Green Process. Synth. 2019, 8, 38–45. [Google Scholar] [CrossRef]
- Taghavi Fardood, S.; Ramazani, A.; Golfar, Z.; Woo Joo, S. Green Synthesis of α-Fe2O (hematite) Nanoparticles using Tragacanth Gel. J. Appl. Chem. Res. 2017, 11, 19–27. [Google Scholar]
- Maksoud, M.A.; Fahim, R.A.; Bedir, A.G.; Osman, A.I.; Abouelela, M.M.; El-Sayyad, G.S.; Abd Elkodous, M.; Mahmoud, A.S.; Rabee, M.M.; Ala’a, H. Engineered magnetic oxides nanoparticles as efficient sorbents for wastewater remediation: A review. Environ. Chem. Lett. 2021, 20, 519–562. [Google Scholar] [CrossRef]
- Sarkar, J.; Mollick, M.; Rahaman, M.; Chattopadhyay, D.; Acharya, K. An eco-friendly route of γ-Fe2O3 nanoparticles formation and investigation of the mechanical properties of the HPMC-γ-Fe2O3 nanocomposites. Bioprocess Biosyst. Eng. 2017, 40, 351–359. [Google Scholar] [CrossRef]
- Ezealigo, U.S.; Ezealigo, B.N.; Aisida, S.O.; Ezema, F.I. Iron oxide nanoparticles in biological systems: Antibacterial and toxicology perspective. JCIS Open 2021, 4, 100027. [Google Scholar] [CrossRef]
- Olga, M.; Jana, M.; Anna, M.; Irena, K.; Jan, M.; Alena, Č. Antimicrobial properties and applications of metal nanoparticles biosynthesized by green methods. Biotechnol. Adv. 2022, 58, 107905. [Google Scholar]
- El-Saadony, M.T.; Sitohy, M.Z.; Ramadan, M.F.; Saad, A.M. Green nanotechnology for preserving and enriching yogurt with biologically available iron (II). Innov. Food Sci. Emerg. Technol. 2021, 69, 102645. [Google Scholar] [CrossRef]
- Bhat, J.A.; Bhat, M.A.; Abdalmegeed, D.; Yu, D.; Chen, J.; Bajguz, A.; Ahmad, A.; Ahmad, P. Newly-synthesized iron-oxide nanoparticles showed synergetic effect with citric acid for alleviating arsenic phytotoxicity in soybean. Environ. Pollut. 2022, 295, 118693. [Google Scholar] [CrossRef]
- Noor, R.; Yasmin, H.; Ilyas, N.; Nosheen, A.; Hassan, M.N.; Mumtaz, S.; Khan, N.; Ahmad, A.; Ahmad, P. Comparative analysis of iron oxide nanoparticles synthesized from ginger (Zingiber officinale) and cumin seeds (Cuminum cyminum) to induce resistance in wheat against drought stress. Chemosphere 2022, 292, 133201. [Google Scholar] [CrossRef]
- Periakaruppan, R.; Li, J.; Mei, H.; Yu, Y.; Hu, S.; Chen, X.; Li, X.; Guo, G. Agro-waste mediated biopolymer for production of biogenic nano iron oxide with superparamagnetic power and antioxidant strength. J. Clean. Prod. 2021, 311, 127512. [Google Scholar] [CrossRef]
- Naz, S.; Islam, M.; Tabassum, S.; Fernandes, N.F.; Carcache de Blanco, E.J.; Zia, M. Green synthesis of hematite (α-Fe2O3) nanoparticles using Rhus punjabensis extract and their biomedical prospect in pathogenic diseases and cancer. J. Mol. Struct. 2019, 1185, 1–7. [Google Scholar] [CrossRef]
- Zhang, W.; Rittmann, B.; Chen, Y. Size Effects on Adsorption of Hematite Nanoparticles on E. coli cells. Environ. Sci. Technol. 2011, 45, 2172–2178. [Google Scholar] [CrossRef]
- Rahmani, M.B.; Ghasemi, E.; Rezaii, F. Synthesis of Wormlike α-Fe2O3 Nanostructure: Characteri-zation and Antibacterial Application. J. Electron. Mater. 2020, 49, 6087–6095. [Google Scholar] [CrossRef]
- Annamalai, J.; Ummalyma, S.B.; Pandey, A.; Bhaskar, T. Recent trends in microbial nanoparticle synthesis and potential application in environmental technology: A comprehensive review. Environ. Sci. Pollut. Res. 2021, 28, 49362–49382. [Google Scholar] [CrossRef]
- Tran, N.; Mir, A.; Mallik, D.; Sinha, A.; Nayar, S.; Webster, T.J. Bactericidal effect of iron oxide nanoparticles on Staphylococcus aureus. Int. J. Nanomed. 2010, 5, 277–283. [Google Scholar] [CrossRef]
- Azam, A.; Ahmed, A.S.; Oves, M.; Khan, M.S.; Habib, S.S.; Memic, A. Antimicrobial activity of metal oxide nanoparticles against Gram-positive and Gram-negative bacteria: A comparative study. Int. J. Nanomed. 2012, 7, 6003–6009. [Google Scholar] [CrossRef] [PubMed]
- Kohanski, M.A.; Dwyer, D.J.; Hayete, B.; Lawrence, C.A.; Collins, J.J. A common mechanism of cellular death induced by bactericidal antibiotics. Cell 2007, 130, 797–810. [Google Scholar] [CrossRef] [PubMed]
- Sies, H. Oxidative stress: Oxidants and antioxidants. Exp. Physiol. Transl. Integr. 1997, 82, 291–295. [Google Scholar] [CrossRef]
- Lee, C.; Kim, J.Y.; Lee, W.I.; Nelson, K.L.; Yoon, J.; Sedlak, D.L. Bactericidal effect of zero-valent iron nanoparticles on Escherichia coli. Environ. Sci. Technol. 2008, 42, 4927–4933. [Google Scholar] [CrossRef]
- Xie, Y.; He, Y.; Irwin, P.L.; Jin, T.; Shi, X. Antibacterial activity and mechanism of action of zinc oxide nanoparticles against Campylobacter jejuni. Appl. Environ. Microbiol. 2011, 77, 2325–2331. [Google Scholar] [CrossRef]
- Khan, A.; Roy, A.; Bhasin, S.; Emran, T.B.; Khusro, A.; Eftekhari, A.; Moradi, O.; Rokni, H.; Karimi, F. Nanomaterials: An alternative source for biodegradation of toxic dyes. Food Chem. Toxicol. 2022, 164, 112996. [Google Scholar] [CrossRef]
- Fouda, A.; Hassan, S.E.-D.; Saied, E.; Hamza, M.F. Photocatalytic degradation of real textile and tannery effluent using biosynthesized magnesium oxide nanoparticles (MgO-NPs), heavy metal adsorption, phytotoxicity, and antimicrobial activity. J. Environ. Chem. Eng. 2021, 9, 105346. [Google Scholar] [CrossRef]
- Saad, M.; Tahir, H.; Khan, J.; Hameed, U.; Saud, A. Synthesis of polyaniline nanoparticles and their application for the removal of Crystal Violet dye by ultrasonicated adsorption process based on Response Surface Methodology. Ultrason. Sonochem. 2017, 34, 600–608. [Google Scholar] [CrossRef]
- Rufus, A.; Sreeju, N.; Philip, D. Size tunable biosynthesis and luminescence quenching of nanostructured hematite (α-Fe2O3) for catalytic degradation of organic pollutants. J. Phys. Chem. Solids 2019, 124, 221–234. [Google Scholar] [CrossRef]
- Popov, N.; Ristić, M.; Bošković, M.; Perović, M.; Musić, S.; Stanković, D.; Krehula, S. Influence of Sn doping on the structural, magnetic, optical and photocatalytic properties of hematite (α-Fe2O3) nanoparticles. J. Phys. Chem. Solids 2022, 161, 110372. [Google Scholar] [CrossRef]
- Jain, A.; Wadhawan, S.; Mehta, S. Biogenic synthesis of non-toxic iron oxide NPs via Syzygium aromaticum for the removal of methylene blue. Environ. Nanotechnol. Monit. Manag. 2021, 16, 100464. [Google Scholar] [CrossRef]
- Routoula, E.; Patwardhan, S.V. Degradation of anthraquinone dyes from effluents: A review focusing on enzymatic dye degradation with industrial potential. Environ. Sci. Technol. 2020, 54, 647–664. [Google Scholar] [CrossRef] [PubMed]
- Bibi, I.; Nazar, N.; Ata, S.; Sultan, M.; Ali, A.; Abbas, A.; Jilani, K.; Kamal, S.; Sarim, F.M.; Khan, M.I.; et al. Green synthesis of iron oxide nanoparticles using pomegranate seeds extract and photocatalytic activity evaluation for the degradation of textile dye. J. Mater. Res. Technol. 2019, 8, 6115–6124. [Google Scholar] [CrossRef]
- Bezbaruah, A.N.; Krajangpan, S.; Chisholm, B.J.; Khan, E.; Elorza Bermudez, J.J. Entrapment of iron nanoparticles in calcium alginate beads for groundwater remediation applications. J. Hazard. Mater. 2009, 166, 1339–1343. [Google Scholar] [CrossRef]
- Meenachi, S.; Kandasamy, S. Investigation of tannery liming waste water using green synthesised iron oxide nano particles. Int. J. Environ. Anal. Chem. 2019, 99, 1286–1297. [Google Scholar]
- Qureshi, K.; Ahmad, M.Z.; Bhatti, I.A.; Zahid, M.; Nisar, J.; Iqbal, M. Graphene oxide decorated ZnWO4 architecture synthesis, characterization and photocatalytic activity evaluation. J. Mol. Liq. 2019, 285, 778–789. [Google Scholar] [CrossRef]
- El-Naggar, M.E.; Shoueir, K. Recent advances in polymer/metal/metal oxide hybrid nanostructures for catalytic applications: A review. J. Environ. Chem. Eng. 2020, 8, 104175. [Google Scholar]
- Li, Z.; Chen, Z.; Zhu, Q.; Song, J.; Li, S.; Liu, X. Improved performance of immobilized laccase on Fe3O4@C-Cu2+ nanoparticles and its application for biodegradation of dyes. J. Hazard. Mater. 2020, 399, 123088. [Google Scholar] [CrossRef]
- Chiarello, L.M.; Mittersteiner, M.; de Jesus, P.C.; Andreaus, J.; Barcellos, I.O. Reuse of enzymatically treated reactive dyeing baths: Evaluation of the number of reuse cycles. J. Clean. Prod. 2020, 267, 122033. [Google Scholar] [CrossRef]
- Xu, X.; Yu, J.; Liu, C.; Yang, G.; Shi, L.; Zhuang, X. Xanthated chitosan/cellulose sponges for the efficient removal of anionic and cationic dyes. React. Funct. Polym. 2021, 160, 104840. [Google Scholar] [CrossRef]

| Compounds | Inhibition Zone/mm | ||||||
|---|---|---|---|---|---|---|---|
| E. coli | P. aeruginosa | B. subtilis | S. mutans | C. albicans | A. fumigatus | ||
| Hem-NPs (µg/mL) | 4000 | 37.3 ± 1.52 a | 0 ± 0.00 | 39.00 ± 1.00 a | 46.33 ± 1.15 a | 14.13 ± 0.81 a | 43.13 ± 1.03 a |
| 2000 | 31 ± 1.00 b | 0 ± 0.00 | 34.67 ± 0.58 b | 40.93 ± 0.9 b | 8.67 ± 0.58 b | 35.23 ± 0.68 b | |
| 1000 | 24.3 ± 1.15 c | 0 ± 0.00 | 30.83 ± 0.76 c | 35.63 ± 0.55 c | 0 ±0. 00 c | 28.33 ± 0.58 c | |
| 500 | 18.5 ± 0.5 d | 0 ± 0.00 | 25.40 ± 0.53 d | 29.33 ± 0.58 d | 0 ± 0.00 c | 24.07 ± 0.90 d | |
| 250 | 12.8 ± 0.76 e | 0 ± 0.00 | 20.17 ± 0.76 e | 22.00 ± 1.00 e | 0 ± 0.00 c | 18.30 ± 0.52 e | |
| 125 | 8.3 ± 0.57 f | 0 ± 0.00 | 16.00 ± 1.00 f | 17.83 ± 0.29 f | 0 ± 0.00 c | 13.90 ± 0.66 f | |
| 62.5 | 0 ± 0.00 g | 0 ± 0.00 | 10.57 ± 0.81 g | 13.30 ± 0.75 g | 0 ± 0.00 c | 9.00 ± 1.00 g | |
| 31.25 | 0 ± 0.00 g | 0 ± 0.00 | 8.33 ± 0.58 h | 10.33 ± 0.58 h | 0 ± 0.00 c | 0 ± 0.00 h | |
| 15.62 | 0 ± 0.00 g | 0 ± 0.00 | 0 ± 0.00 i | 8.23 ± 0.40 i | 0 ± 0.00 c | 0 ± 0.00 h | |
| 7.81 | 0 ± 0.00 g | 0 ± 0.00 | 0 ± 0.00 i | 0 ± 0.00 j | 0 ± 0.00 c | 0 ± 0.00 h | |
| 3.9 | 0 ±0.00 g | 0 ± 0.00 | 0 ± 0.00 i | 0 ± 0.00 j | 0 ± 0.00 c | 0 ± 0.00 h | |
| BF * | 0 ± 0.00 | 0 ±0.00 | 0 ± 0.00 | 0 ± 0.00 | 0 ± 0.00 | 0 ± 0.00 | |
| CXM/NS ** | 12.2 ± 0.44 | 0 ± 0.00 | 0 ± 0.00 | 0 ± 0.00 | 11.7 ± 0.35 | 0 ± 0.00 | |
Publisher’s Note: MDPI stays neutral with regard to jurisdictional claims in published maps and institutional affiliations. |
© 2022 by the authors. Licensee MDPI, Basel, Switzerland. This article is an open access article distributed under the terms and conditions of the Creative Commons Attribution (CC BY) license (https://creativecommons.org/licenses/by/4.0/).
Share and Cite
Saied, E.; Salem, S.S.; Al-Askar, A.A.; Elkady, F.M.; Arishi, A.A.; Hashem, A.H. RETRACTED: Mycosynthesis of Hematite (α-Fe2O3) Nanoparticles Using Aspergillus niger and Their Antimicrobial and Photocatalytic Activities. Bioengineering 2022, 9, 397. https://doi.org/10.3390/bioengineering9080397
Saied E, Salem SS, Al-Askar AA, Elkady FM, Arishi AA, Hashem AH. RETRACTED: Mycosynthesis of Hematite (α-Fe2O3) Nanoparticles Using Aspergillus niger and Their Antimicrobial and Photocatalytic Activities. Bioengineering. 2022; 9(8):397. https://doi.org/10.3390/bioengineering9080397
Chicago/Turabian StyleSaied, Ebrahim, Salem S. Salem, Abdulaziz A. Al-Askar, Fathy M. Elkady, Amr A. Arishi, and Amr H. Hashem. 2022. "RETRACTED: Mycosynthesis of Hematite (α-Fe2O3) Nanoparticles Using Aspergillus niger and Their Antimicrobial and Photocatalytic Activities" Bioengineering 9, no. 8: 397. https://doi.org/10.3390/bioengineering9080397
APA StyleSaied, E., Salem, S. S., Al-Askar, A. A., Elkady, F. M., Arishi, A. A., & Hashem, A. H. (2022). RETRACTED: Mycosynthesis of Hematite (α-Fe2O3) Nanoparticles Using Aspergillus niger and Their Antimicrobial and Photocatalytic Activities. Bioengineering, 9(8), 397. https://doi.org/10.3390/bioengineering9080397

